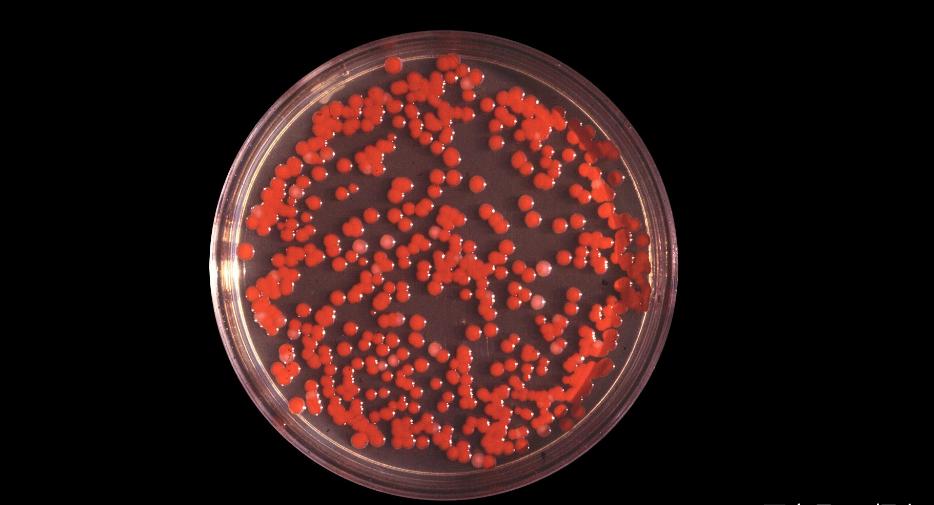
1950年的美国的生化危机,旧金山生化危机

在阅读此文前,麻烦您点击一下“关注”,既方便您进行讨论与分享,又给您带来不一样的参与感,感谢您的支持。
近几年,“生化危机”在各个国家的灾难片中都算得上是炙手可热的主题了,感染于无形的大规模流行病,在荧屏中营造出一幕又一幕末世的绝望氛围。
但是,如果说在美国本土曾经有过真正的涉及80万人的“生化危机”,并且这场“生化危机”还跟美国政府相关,你相信吗?

零号病人唯一的死亡病例
1950年9月的某一天,美国旧金山有一位叫*爱做**德华▪内文的老人没有如往常一样到他最喜欢的公园里散步。
如果说我国的昆明是四季如春的春城,那么旧金山就是四季如秋的秋城。旧金山位于美国西海岸,是美国的第三大城市。
常年温度在10到25摄氏度之间,大多时候天气晴朗,海风温润。

在旧金山这样一个城市里生活,早晚散步是爱德华每天最喜欢的事情之一。但最近,不知道为什么爱德华觉得自己身体十分虚弱,浑身无力。
更严重的是,这个早晨起来上厕所的时候,他惊讶的发觉自己似乎又尿血了,小便呈一种十分不正常的鲜红色。

之所以说“又”那是因为爱德华不久之前刚做完一个前列腺手术,在那之前,他的泌尿系统就不太健康。
手术之后,医生也反复交代,要爱德华特别关注小便情况。
如今好不容易基本康复的爱德华又再次出现尿血,内心也比较警惕。毕竟如果再次手术的话,不仅会给家里带来更重的经济负担,感恩节也只能在医院度过了。

怀着忐忑的心情,爱德华再次来到了斯坦福医院。
但无论如何,期待着再次治疗之后就可以在家跟家人一起度过感恩节的爱德华完全没有想到,他再也没能走出斯坦福医院。
同时,成为了历史记载的这一场“生化危机”中唯一官方承认的死亡案例。

接诊爱德华的医生刚开始也以为爱德华只是常见的手术后泌尿系统的再感染,于是,安排爱德华做了一系列常规的检查,等检查结果出来之后,就可以进行对应的治疗。可是,当爱德华的检查报告出来的时候,医生极为震惊。
因为爱德华的检查报告显示,他感染了一种看似平常无害又根本不应该出现的细菌:粘质沙雷氏菌。

怀着满腹的狐疑,医生问爱德华最近去过哪些地方,是不是出过远门。爱德华一脸无辜的说,他从未远离过这座城市。
粘质沙雷氏菌从它本身来说并没有什么特别,甚至可以说这种在地球上广泛存在的细菌对人体也几乎没有什么害处。
唯一不对的地方在于它出现的地方,如果说爱德华没有离开过旧金山,那么他不可能有机会感染到这种当地从来没有过的细菌。
但粘质沙雷氏菌的“无害”也只是针对绝大多数健康人群而言的,对于爱德华这样身体较差的人来说,情况就不乐观了。
粘质沙雷氏菌专挑体质薄弱的人攻击,而根据之前的经验,泌尿系统是这种细菌最爱入侵的部位。

医生来不及更加详细的探寻爱德华感染上粘质沙雷氏菌的缘由,仅仅一个月之后,爱德华就因细菌的全身感染而不治身亡。
真枪实弹的病毒实验
随后一段时间斯坦福医院接连接诊了数十个由于粘质沙雷氏菌而引起不适的病例,所幸的是没有再出现死亡。
当斯坦福的医生们竭尽全力的救治病人的时候,他们肯定无法想象,这些粘质沙雷氏菌居然是在一个月前由美国自己的军舰亲自散播在旧金山海岸的。

时间来到一个月以前,也是在一个平凡无奇的早晨,三艘美军军舰静悄悄的来到了旧金山海岸线附近。
没有人知道,这三艘美国军舰居然干了一件惊天地泣鬼神至今都很难想象的事,它们奉命对旧金山释放了带有粘质沙雷氏菌的毒雾,真真正正的发起了生化攻击。

为什么美国军方要这么做呢?首先,在那个特殊的时间里,虽然二战已经结束,但是美国对于本土的安全依然十分警惕。
特别是对于太平洋彼岸的日本,美国军事专家们认为日本总是不守规矩不宣而战,甚至想过用热气球搭载*器武**攻击美国本土,非常有可能采取被世界所不齿的“生化攻击”。害怕他国发起生化攻击的解决办法为什么是对自己发动生化攻击?

我们从来没有见过消防演习就真的烧掉一栋楼,地震演习就真的发起一场地震,美国军方却想到了用发起生化攻击来进行生化实验。
美国军方的想法也很简单,自己给自己下个毒,检验一下国民的抵抗力以及相关部门的反应,这样不就知道了自己抵抗生化攻击的能力到了什么程度?

由于旧金山位于美国西海岸,美国军方认为如果日本或者其他国家发起生化攻击,旧金山很有可能成为首选。
其次,旧金山是美国的第三大城市,拥有80万人口,人口密集更加有利于生化细菌、病毒迅速传播观察相应影响。第三,旧金山气候适宜,也有细菌生存的良好环境。

虽然对于民众来说,被自己的国家“下毒”做实验这种事是很难想象的。但是美国军方认为,他们选择了安全的粘质沙雷氏菌。
这种细菌对绝大多数健康人都是无害的,并且容易传播。粘质沙雷氏菌跟有机体结合还容易显现出独特的鲜红色,也很容易取得观察样本。

事实上,这样一场由本国军方发动的生化攻击,让旧金山80万人陷入了无形的危险之中。
原本没有粘制沙雷氏菌的生态环境在受到细菌污染之后会发生什么样的变化,谁也说不清楚。虽然官方没有更多的详细记载,但至少在这场涉及80万人的“生化危机”里,至少有一位爱德华老人失去了宝贵的生命。

在出现爱德华事件之后,美国军方也重新评估了生化实验粘质沙雷氏菌的安全性,承认了其风险。
但事实上,在往后的几十年里,美国政府继续在本国各个城市发起了两百多次生化实验,其中包括机场和地铁站。

无论这样的生化实验目的是什么,也无论是否在这些生化实验里死亡人数到底是不是只有一个。这样的“生化危机”实在是不应该发生的啊!